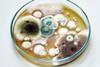
funal-contamination-FI

All Article articles – Page 13
-
 Article
ArticleDivest to invest: the new normal in biopharma?
Subin Baral, EY Global Deals Leader for Life Sciences, a partner at Ernst & Young LLP, shares exclusive insight on how strategies such as specialisation can help life science companies secure future growth and the key role divestments and spin-outs have on ensuring this strategic focus.
-
 Article
ArticleATRAG formulations for lung disease
Carl-Johan Dalsgaard, CEO of Vicore Pharma speaks to EPR about clinical trials of C21, an angiotensin II type 2 receptor agonist developed to treat rare lung diseases – and the first ever ATRAG to reach clinical-stage development.
-
 Article
ArticleTreating Alzheimer’s: regulatory hurdles in an anti-amyloid revolution
In this article, Gareth Morgan, a life sciences partner at Pinsent Masons discusses how Leqembi validates the anti-amyloid approach for treating Alzheimer’s, and whether its recent regulatory authorisations could support fast-tracking approvals of other promising Alzheimer’s therapies.
-
 Article
ArticleRegenerative potential: cell‑based therapies for heart failure
Cell-based therapies have the potential to regenerate heart tissue as an alternative to heart transplants. Here, Dr Ibon Garitaonandia, Chief Scientific Officer at CellProthera, shares how CD34+ cells are demonstrating promising results in clinical studies.
-
 Article
ArticleDigitalising HPLC methods: the path to interoperability
Transferring analytical methods between companies is often a challenging, time-consuming manual process. In this Q&A, Dr Birthe Nielsen, Project Lead at The Pistoia Alliance, speaks about an ongoing project to digitally transfer HPLC data between different vendors.
-
 Article
ArticleStrengthening and transforming the pharmaceutical supply chain
In this exclusive interview, Naser Al Yammahi, Deputy CEO of Hayat Biotech explores challenges facing the pharmaceutical supply chain, medicine shortages and looks at how technology advances will drive supply chain transformation.
-
 Article
ArticleThe evolution of AAVs in cell and gene therapy
AAV development for cell and gene therapy in 2023 is being impacted by manufacturing and regulation challenges, however advancing technologies offer opportunity, according to leaders in the field.
-
 Article
ArticlePreparing for stricter standards on substances of human origin
Manufacturers of innovative therapies and other stakeholders handling blood, tissues and cells must prepare for stronger European rules. Ulf Grundmann, Elisabeth Kohoutek and Lara Sophie Hucklenbroich of King & Spalding elaborate on what this means for manufacturers of advanced therapy medicinal products.
-
 Article
ArticleRe-engineering proteins to develop novel immunotherapies
Jessicca Rege of Alkermes provides insights into how protein engineering approaches have led to the development of novel therapies that harness the immune system’s capabilities to fight cancer.
-
 Article
ArticleThe future of medical cannabis development in Europe
Dr Mikael Sodergren, Chief Medical Officer at Curaleaf International, discusses the challenges of developing and researching medical cannabis products and how the European medical cannabis ecosystem is well placed to overcome them.
-
 Article
ArticleOn the clock: a collaborative approach to advancing adoption of RMM
EPR’s Caroline Peachey explores collaborative efforts to accelerate validation and adoption of rapid microbial methods across the pharmaceutical industry.
-
Article
ArticleThe power of rapid methods for fungal ID
By leveraging rapid identification techniques, pharmaceutical facilities can enhance their ability to detect and mitigate fungal contamination, safeguarding product quality and patient safety. Here, Dr Tim Sandle explores key challenges associated with fungal contamination in cleanrooms, discusses conventional and rapid identification methods, as well as the importance of validation.
-
 Article
ArticleCapsule formulation: future trends
In this Q&A, Recipharm’s Torkel Gren discusses developments in capsule formulation, including the shift away from gelatine and the potential for growth in the inhalation capsule market.
-
 Article
ArticleTitanium dioxide (E171) and its role in formulation
In this article Mike Tobyn from Bristol Myers Squibb, Jonathan Kaye from GSK, David Harris from MSD and Eli Lilly’s Jason Melnick discuss the role of E171 (titanium dioxide) in the identification of solid oral dosage forms.
-
Article
Recommendations and considerations for bacteriophage therapy usage in clinical settings
Phage therapy holds great promise as a new therapeutic option in the face of increasing antimicrobial resistance, but sound clinical data remains a stumbling block to its application. Here, Snehit Satish Mhatre from Eurofins Biopharma Product Testing outlines key considerations to address when designing clinical trials.
-
 Article
ArticleGuide to Data Integrity
Welcome to EPR's Guide to Data Integrity. In this edition, Charles River explores the significance of data integrity in pharmaceutical manufacturing, Graeme Bones of ICON considers how to complete database transfer with data integrity considerations at the forefront and Rapid Micro Biosystems® discusses the practical implications of the ‘four-eyes principle’ ...
-
 Article
ArticleFormulation In-Depth Focus 2023
This in-depth focus features articles on trends in capsule formulation and the evolving role of titanium dioxide in formulation.
-
 Article
ArticleInternational regulation: the importance of quality assurance in drug development
Raquera Brown, Executive Director of Quality at Zymeworks offers quality and compliance professionals advice on how to navigate the often-complex regulatory space during development of innovative drugs like antibody therapeutics.
-
 Article
ArticleIn Depth Focus QA/QC Microbiology/RMM 2023
This in-depth focus explores collaborative efforts to accelerate validation and adoption of rapid microbial methods across the pharmaceutical industry and the power of rapid methods for fungal ID.
-
 Article
ArticleReflecting on five years of quality control for nitrosamine impurities
Since the US Food and Drug Administration (FDA)’s report on a series of nitrosamine-related impurity drug recalls in 2018, pharma has made great strides in its ability to detect and control for these impurities. Dr Mrunal Jaywant, Vice President of R&D at USP India proposed a collaborative, cross-community approach between ...



